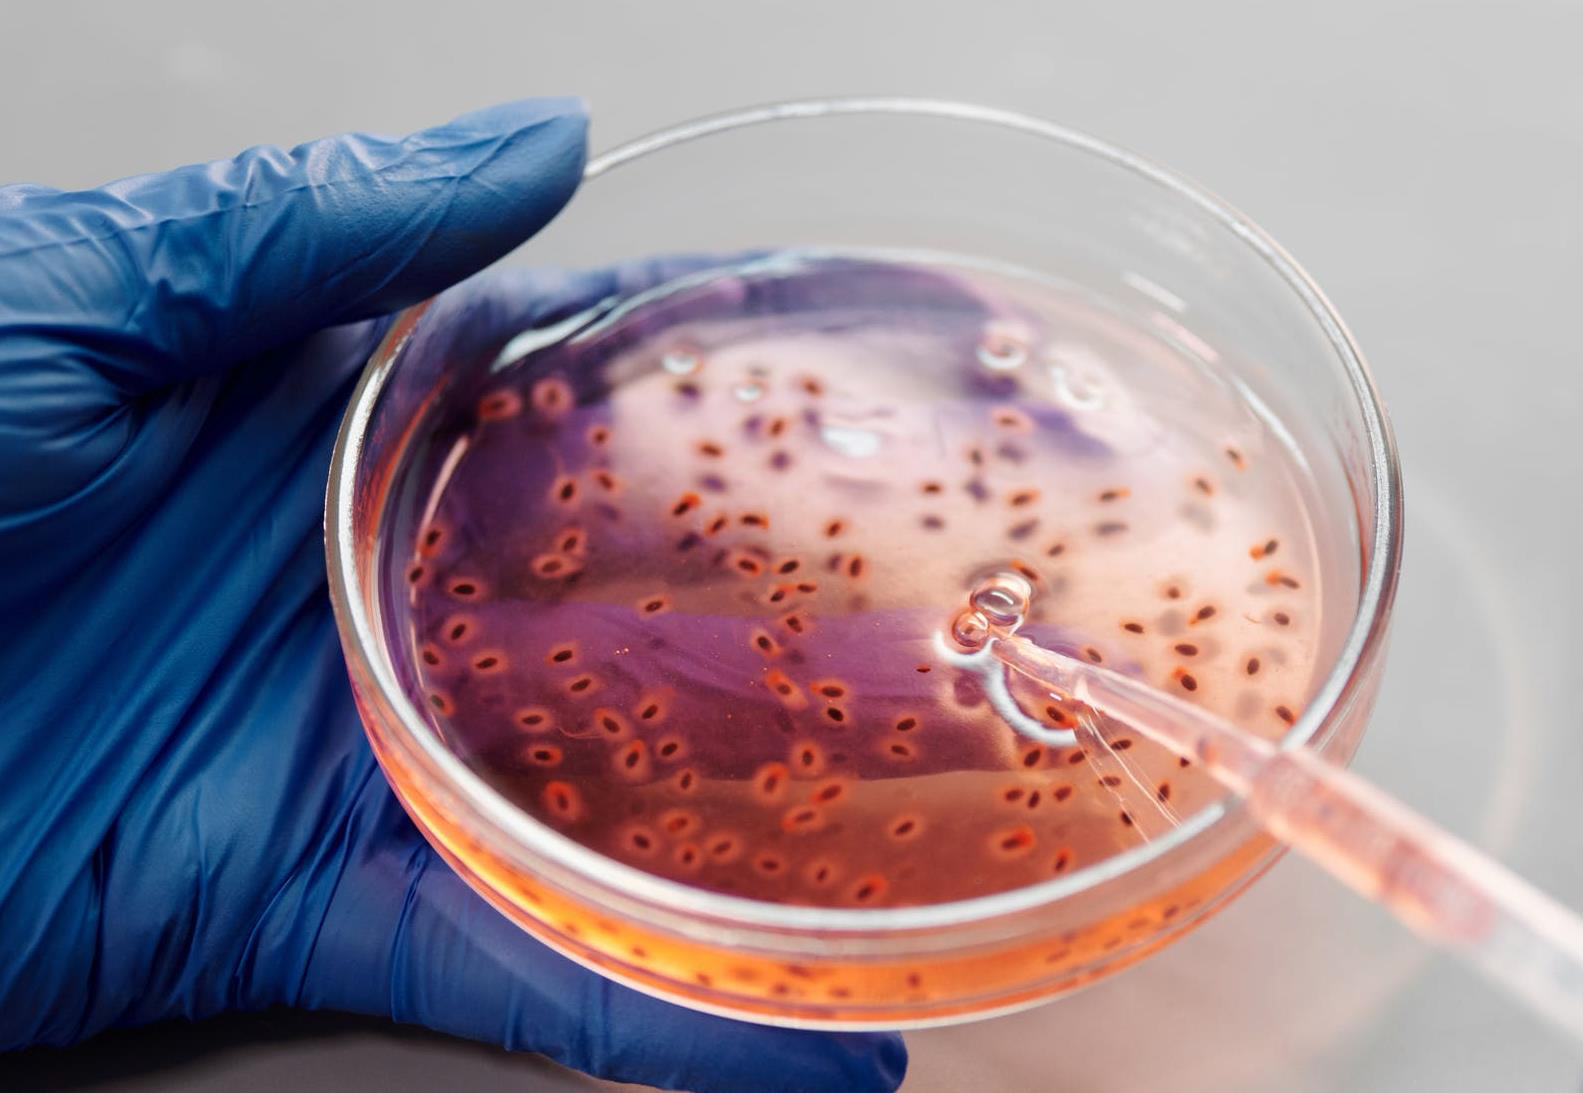

EL NACIMIENTO DE MERCATUS

NUESTRA TECNOLOGÍA
Con una longitud de onda que va de 200 nm a 300 nm, la UV-C es la única luz ultravioleta germicida, con un pico de efectividad de 254 nm. Nuestras lámparas irradian aproximadamente el 95% de su energía a una longitud de onda de 253,7 nm, que es el pico de absorción del ADN.
La absorción por el ADN y el ARN hace que las células sean estériles, mientras que la absorción por las proteínas conduce a la ruptura de las paredes celulares y posteriormente a su muerte.

La ciencia detrás
"La eficacia de la radiación UV-C para reducir los recuentos de bacterias vegetativas en superficies fue más del 99,9% en 15 minutos, y la reducción de las esporas de C. Difficile fue del 99,8% en 50 minutos."
Título: Room Decontamination with UV Radiation Autor: W. A. Rutala , M. F. Gergen , D. J. Weber Publication: Infection Control & Hospital Epidemiology Fecha: Jan 2, 2015

“UV-C es una herramienta poderosa que se puede aplicar ampliamente en una amplia gama de instituciones públicas, incluidos hospitales, hogares de ancianos, lugares de trabajo, escuelas, aeropuertos y centros comerciales para desinfectar equipos y superficies contaminados, así como para prevenir y reducir la transmisión por contacto con el SARS-CoV-2."
Título: Rapid and complete inactivation of SARS-CoV-2 by ultraviolet-C irradiation Autor: N. Storm, L. G. A. McKay, S. N. Downs, et al Fecha: Dec 30, 2020

INDUSTRIAS

Una poderosa herramienta para luchar contra el COVID-19
La Universidad de Boston ha realizado un estudio para demostrar que la luz Ultravioleta puede eliminar eficazmente el SARS-CoV-2. La Sociedad Americana de Ingenieros de Calefacción, Refrigeración y Aire Acondicionado ha recomendado la irradiación germicida ultravioleta como una de las estrategias para abordar la transmisión del COVID-19.
La Asociación Internacional de Ultravioleta (IUVA) publicó un documento en el que se destacaba que la desinfección normal puede dejar cierta contaminación residual, que la UV-C puede eliminar eficazmente.
WonderXcart
Ciclos probados, tasas de mortalidad efectivas
Sterisafe
10 mJ/cm2
Steriplus
30 mJ/cm2
Steriultra
100 mJ/cm2

Características del Producto

WonderXCabinet
Eficaz para los virus y las bacterias más duras
Sterisafe
Steriplus
Steriultra

Características del Producto


¿Qué es la fotocatálisis?
La exposición al aire de la lámpara especial UV-C dentro de la cámara de purificación con catalizador la transforma en fotoplasma.
¿Qué es el fotoplasma?
Es una mezcla de radicales hidroxilo y iones negativos que reaccionan y eliminan microorganismos.
¿Radicales de hidroxilo?
33% más efectivos que el ozono y 2,5 veces más bactericidas y esporádicos que el cloro.
WonderXPure
Silencioso y eficaz, elimina virus y bacterias día tras día.
* Próximamente
Purifica el aire que respiras
Steriultra

WonderXRobot
Automatiza las tareas más complicadas para que su personal se concentre en realizar un mejor trabajo.
Garantiza un entorno seguro
SteriUltra
100 mJ/cm2

Características del Producto


Control Remoto
Establecer y gestionar todas las operaciones desde cualquier lugar, en cualquier momento
Fácil de Configurar
Diseño fácil de usar para una configuración y navegación intuitiva del ciclo
Registro de ciclo automático
Dispone de un registrador de datos de desinfección
Monitoreo Remoto
Monitorizar el estado, las alarmas y las advertencias en tiempo real



